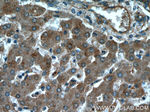
PYGM Antibody in Immunohistochemistry (Paraffin) (IHC (P))

Search
Proteintech
PYGM Polyclonal Antibody
{{$productOrderCtrl.translations['antibody.pdp.commerceCard.promotion.promotions']}}
{{$productOrderCtrl.translations['antibody.pdp.commerceCard.promotion.viewpromo']}}
{{$productOrderCtrl.translations['antibody.pdp.commerceCard.promotion.promocode']}}: {{promo.promoCode}} {{promo.promoTitle}} {{promo.promoDescription}}. {{$productOrderCtrl.translations['antibody.pdp.commerceCard.promotion.learnmore']}}
产品信息
19716-1-AP
种属反应
宿主/亚型
分类
类型
抗原
偶联物
形式
浓度
规格
纯化类型
保存液
内含物
保存条件
运输条件
产品详细信息
The antibody is specific to PYGM.
靶标信息
This gene encodes a muscle enzyme involved in glycogenolysis. Highly similar enzymes encoded by different genes are found in liver and brain. Mutations in this gene are associated with McArdle disease (myophosphorylase deficiency), a glycogen storage disease of muscle. Alternative splicing results in multiple transcript variants.
仅用于科研。不用于诊断过程。未经明确授权不得转售。
生物信息学
蛋白别名: glycogen muscle; Glycogen phosphorylase, muscle form; GPMM; muscle (McArdle syndrome); muscle glycogen phosphorylase; Myophosphorylase; Phosphorylase glycogen; phosphorylase, glycogen, muscle; Phosphorylase, glycogen; muscle (McArdle syndrome); unnamed protein product
基因别名: AI115133; GSD5; Muscpho; PG; PYGM
UniProt ID: (Human) P11217, (Mouse) Q9WUB3
Entrez Gene ID: (Human) 5837, (Rat) 24701, (Mouse) 19309